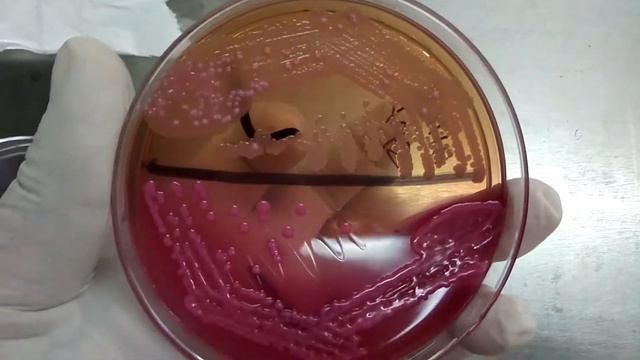
Klebsiella pneumoniae and Acinetobacter Colony characteristics on Macconkey medium Demonstration смотреть онлайн

Автор: Зеленый путешествие Страница 2

ЦВЕТОК ЛЮБИМОЙ ЖЕНЩИНЕ.

Bridges - Website Portal Master

Установка имплантатов Астра, забор и пересадка твёрдых тканей, реконструкция альвеолярного гребня

Lunes de Farmacopea 25/04/2022

Angel's Trumpet Tree on Salt Spring island

Jade Warrior - Petunia

How to plant gladiolus bulbs

Syrup making set DELLA CASA

Выставка фиалок 29.10.2023. Продолжение.

Plant Maintenance - Fertilising Ep 44

Нужно ваше мнение по поводу этого сеянца
Klebsiella pneumoniae and Acinetobacter Colony characteristics on Macconkey medium Demonstration

Семена кактусов 3 день после посева

DEAG - CAMELLIA BONCUK ÇANTA

4k Quality Tutorial ; Premiere Pro Export Settings + Topaz Settings

GUERLAIN L'INSTANT REVIEW

Мои цветочки в мае

Cattleya hybrid no id. Каттлея без названия

The Wind That Shakes the Barley

Меридиан

Египет, Шарм-эль-Шейх 2021. Отель Sharm Cliff Resort 3*. Комната
![Мистификаторы оружия фарм соло Вуконг прайм [ Без комментариев ] смотреть онлайн](https://pic.rutubelist.ru/video/8d/3b/8d3b529b0a514111ef85f58b849e9d39.jpg?size=m)
Мистификаторы оружия фарм соло Вуконг прайм [ Без комментариев ]

So lecker, dass die Familie darum bittet, es jeden Tag zu kochen! Schnelles und günstiges Gericht!

Alien: Isolation Part 2
За каждым успешным каналом стоит личность, идея и сотни часов кропотливого труда. Если вы здесь, значит, автор «Зеленый путешествие» уже сумел зацепить ваше внимание своим уникальным стилем или подачей. А мы на RUVIDEO позаботились о том, чтобы вы могли изучить весь архив его работ в максимально комфортных условиях — без лишней суеты и преград.
Почему за работами канала «Зеленый путешествие» так интересно наблюдать? Всё просто: это честный контент, который находит отклик в сердцах зрителей. На нашем ресурсе вы можете смотреть онлайн все видео любимого автора бесплатно и в хорошем качестве. Нам важно, чтобы вы видели каждую деталь и слышали каждый нюанс, поэтому мы используем только стабильные плееры из открытых источников Rutube.
Следите за новинками канала, пересматривайте старые шедевры и открывайте для себя новые грани творчества «Зеленый путешествие». Мы постоянно обновляем ленту, чтобы у вас под рукой всегда были самые свежие выпуски. Никаких сложных регистраций — только вы и творчество, которое вдохновляет. Приятного вам путешествия по миру авторского контента на RUVIDEO!
Видео взято из открытых источников Rutube. Если вы правообладатель, обратитесь к первоисточнику.